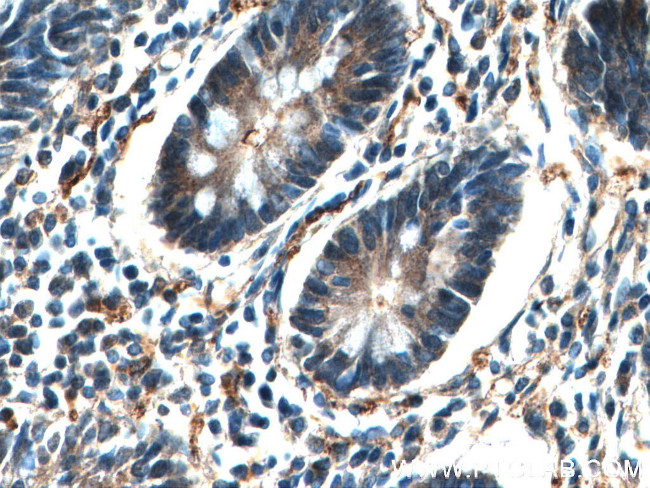
EIF2AK4 Antibody in Immunohistochemistry (Paraffin) (IHC (P))

Search
Proteintech
EIF2AK4 Polyclonal Antibody
{{$productOrderCtrl.translations['antibody.pdp.commerceCard.promotion.promotions']}}
{{$productOrderCtrl.translations['antibody.pdp.commerceCard.promotion.viewpromo']}}
{{$productOrderCtrl.translations['antibody.pdp.commerceCard.promotion.promocode']}}: {{promo.promoCode}} {{promo.promoTitle}} {{promo.promoDescription}}. {{$productOrderCtrl.translations['antibody.pdp.commerceCard.promotion.learnmore']}}
产品信息
27944-1-AP
种属反应
宿主/亚型
分类
类型
抗原
偶联物
形式
浓度
规格
纯化类型
保存液
内含物
保存条件
运输条件
产品详细信息
Sequence of this protein is as follows: AFSADSKQDD QTGDLIKSDP SGHLTGMVGT ALYVSPEVQG STKSAYNQKV DLFSLGIIFF EMSYHPMVTA SERIFVLNQL RDPTSPKFPE DFDDGEHAKQ KSVISWLLNH DPAKRPTATE LLKSELLPPP QMEESELHEV LHHTLTNVDG KAYRTMMAQI FSQRISPAID YTYDSDILKG NFSIRTAKMQ QHVCETIIRI FKRHGA
靶标信息
EIF2AK4 (GCN2) is a metabolic-stress sensing protein kinase that phosphorylates the alpha subunit of eukaryotic translation initiation factor-2 in response to low amino acid availability. It plays a role as an activator of the integrated stress response required for adapatation to amino acid starvation. Mutations in the gene lead to pulmonary vennocclusive disease 2.
仅用于科研。不用于诊断过程。未经明确授权不得转售。
篇参考文献 (0)
生物信息学
蛋白别名: eIF-2-alpha kinase GCN2; Eukaryotic translation initiation factor 2-alpha kinase 4; GCN2 eIF2alpha kinase; GCN2-like protein; general control nonderepressible 2; unnamed protein product
基因别名: EIF2AK4; GCN2; KIAA1338; PVOD2
UniProt ID: (Human) Q9P2K8
Entrez Gene ID: (Human) 440275